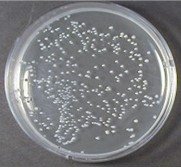
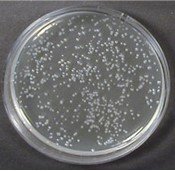
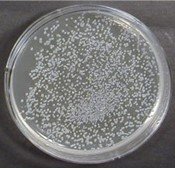
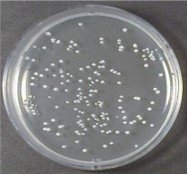
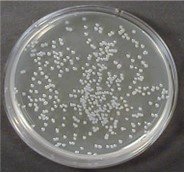
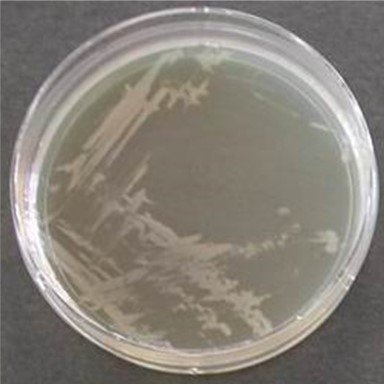
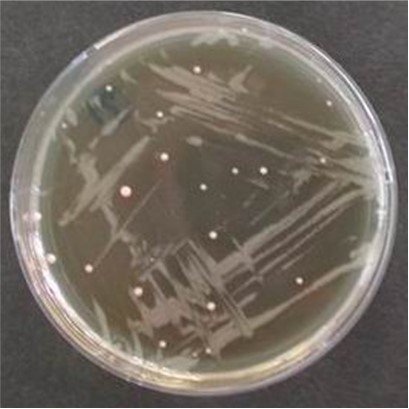
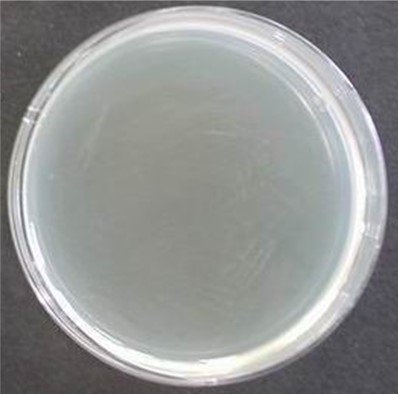
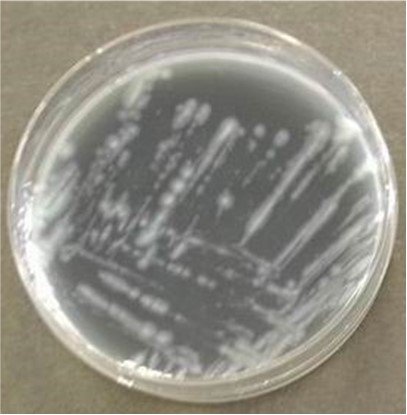
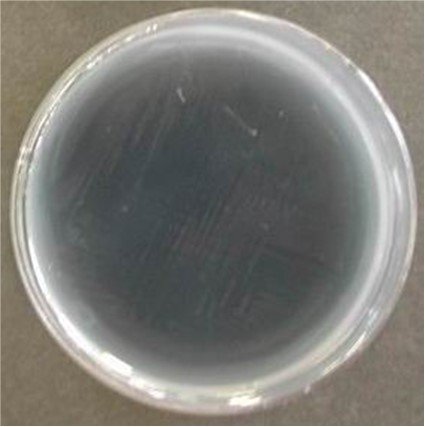
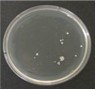
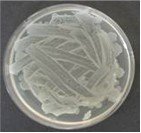

プライムデルタ ミスト~実験の結果まとめ
前述のように、精油には人体にとっていろいろな効果・効能があることが知られています。精神への作用(ストレス緩和や不眠の改善、集中力を高めるなど)や身体への作用(自律神経のバランスやホルモン分泌調整や消化促進、免疫賦活)などがその代表です。
そして強い殺菌・防虫・消臭などの作用も知られています。
プライムデルタミストはこれら「エッセンシャルオイルのちから」をしっかり活かし、消臭・除菌・リラクゼーションのお役に立つ製品となっております。
殺菌力をもつエッセンシャルオイル(ティートリー、ペパーミント、ローズマリー、ラベンダ-など)を様々な割合でブレンドして、実験を重ねた結果、優れた殺菌力をもつ構成成分とその割合を決め、プライムデルタミストのベ-スしました。
そのべ-スを用いた実験の結果を示します。
プライムデルタミストのベ-ス構成成分
- 3種類のエッセンシャルオイル(ティートリー、ペパーミント、ローズマリー)
- エタノ-ル 70%
- グリセリン 5%
- 精製水
プライムデルタミストの殺菌効果
プライムデルタミスト
コントロール
エタノール
レジオネラ属菌
BSYE培地